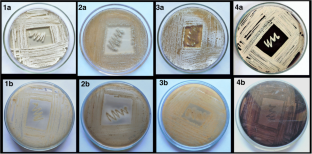
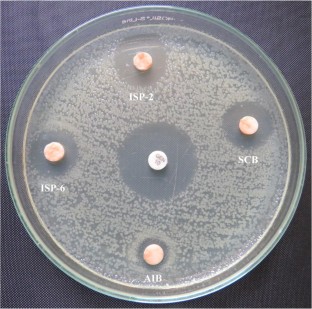

Abstract
Endophytic actinomycetes, a prolific source of natural products, are well known for their diverse metabolic versatility, and their association with medicinal plants and antimicrobial potential are well worth exploring. We isolated and identified the Streptomyces cavourensis strain MH16 inhabiting the tree Millingtonia hortensis Linn. using phylogenetic analysis based on a 16S rRNA molecular approach. We used the disc diffusion method to evaluate the impact of differences in the compositions of the media on the production of secondary metabolites from strain MH16. The production of antimicrobial metabolites was determined by the observation of inhibition zones on intensive bands when using a TLC-bioautography assay. Biosynthesis of secondary metabolites was optimal when the strain MH16 was cultured in ISP-2 medium as depicted by a zone of inhibition. Strain MH16 effectively inhibited methicillin-resistant Staphylococcus aureus, Escherichia coli, Candida albicans, and other multi drug-resistant pathogens. The minimum inhibitory concentration of the antimicrobial metabolites was 25–100 μg mL−1. The study manifests the optimization and utilization of different fermentation media which best suits for increased production of the secondary metabolites from Streptomyces cavourensis. This research suggests that the antimicrobial metabolites of strain MH16 found in M. hortensis has great potential for the biodiscovery of new anti-infective drugs against a wide range of multidrug-resistant pathogens.

Similar content being viewed by others
References
Akshatha VJ, Nalini MS, D’Souza C, Prakash HS (2014) Streptomycete endophytes from anti-diabetic medicinal plants of the Western Ghats inhibit alpha-amylase and promote glucose uptake. Lett Appl Microbiol 58:433–439. https://doi.org/10.1111/lam.12209
Azadeh B, Meon S (2009) Molecular characterization of Pseudomonas aeruginosa UPM P3 from oil palm rhizosphere. American J App Sci 6:1915–1919. https://doi.org/10.3844/ajassp.2009.1915.1919
Baltz RH, Katz L (2016) Natural product discovery: past, present, and future. J Microbiol Biotechnol 43:155–176. https://doi.org/10.1007/s10295-015-1723-5
Berdy J (2005) Bioactive microbial metabolites. J Antibiot 58:1–26. https://doi.org/10.1038/ja.2005.1
Bills GF, Platas G, Fillola A, Jimenez MR, Collado J, Vicente F, Martín J, González A, Bur-Zimmermann J, Tormo JR, Peláez F (2008) Enhancement of antibiotic and secondary metabolite detection from filamentous fungi by growth on nutritional arrays. J Appl Microbiol 104:1644–1658. https://doi.org/10.1111/j.1365-2672.2008.03735.x
Chikezie PC, Ibegbulem CO, Mbagwu FN (2015) Bioactive principles from medicinal plants. Res J Phytochem 9:88–115. https://doi.org/10.3923/rjphyto.2015.88.115
Clinical and Laboratory Standards Institute (2009) Performance standards for antimicrobial disk susceptibility tests; approved standard, 10th Ed. M02-A10.CLSI, Wayne, PA. USA. 10.1309/lm3iltl0tce3rfbt
Donovick R, Gold W, Pagano JF, Stout HA (1955) Amphotericins A and B, antifungal antibiotics produced by a Streptomycete. I. in vitro studies. Antibiotics Ann 3:576–578
Genilloud O (2017) Mining actinomycetes for novel antibiotics in the Omics Era: are we ready to exploit this new paradigm? Antibiotics 7:85–118. https://doi.org/10.1016/j.femsec.2003.12.009
Germaine K, Keogh E, Garcia-Cabellos G, Borremans B, Lelie D (2004) Colonisation of poplar trees by GFP expressing bacterial endophytes. FEMS Microbiol Ecol 48:109–118. https://doi.org/10.1016/j.femsec.2003.12.009
Gupte S, Kaur M, Kaur M (2017) Novel approaches to developing new antibiotics. J Bacteriol Mycol Open Access 4:00089. https://doi.org/10.15406/jbmoa.2017.04.00089
Hewage RT, Aree T, Mahidol C, Ruchirawat S, Kittakoop P (2014) One strain-many compounds (OSMAC) method for production of polyketides, azaphilones, and an isochromanone using the endophytic fungus Dothideomycete sp. Phytochemistry 108:87–94. https://doi.org/10.1016/j.phytochem.2014.09.013
Ho WH, To PC, Hyde KD (2003) Induction of antibiotic production of freshwater fungi using mix-culture fermentation. Fungal Divers 12:45–51
Hofs R, Walker M, Zeeck A (2000) Hexacyclinic acid, a polyketide from Streptomyces with a novel carbon skeleton. Angew Chem Int Ed 39:3259–3261. https://doi.org/10.1002/1521-3773
Jetty A, Iyengar DS (2000) Antimicrobial activity of M. hortensis leaf extract. Pharm Biol 38:157–160. https://doi.org/10.1076/1388-0209(200004)3821-1FT157
Jiang ZK, Tuo L, Huang DL, Osterman IA, Tyurin AP, Liu SW, Lukyanov DA, Sergiev PV, Dontsova OA, Korshun VA, Li FN, Sun CH (2018) Diversity, novelty, and antimicrobial activity of endophytic actinobacteria from mangrove plants in Beilun estuary national nature reserve of Guangxi, China. Front Microbiol 9:868. https://doi.org/10.3389/fmicb.2018.00868
Joutey NT, Bahafid W, Sayel H, Ghachtouli NE (2013) Biodegradation: involved microorganisms and genetically engineered microorganisms. In: Biodegradation - Life of Science. https://doi.org/10.5772/56194
Kaushik R, Saini P (2009) Screening of some semiarid region plants for larvicidal activity against Aedes aegypti mosquitoes. J Vector Borne Dis 46:244–246
Kelly KL (1964) Inter-society color council-national bureau of standards color name charts illustrated with centroid colors. US Government Printing Office, Washington, DC
Kornerup A, Wanscher JH (1978) Methuen handbook of colour. 3rd edn, Methuen, London
Kumar A (2018) Reappraisal of pictographs from Pathipara, Marayoor, district Idukki, Kerala. Heritage: J Multidis Stud Archaeol 6:555–574
Kumari A, Sharma RA (2013) A review on Millingtonia hortensis Linn. Int J Pharm Sci Rev Res 19:85–92
Kusari S, Lamshöft M, Spiteller M (2009) Aspergillus fumigatus Fresenius, an endophytic fungus from Juniperus communis L. Horstmann as a novel source of the anticancer pro-drug deoxypodophyllotoxin. J Appl Microb 107:1019–1030. https://doi.org/10.1111/j.1365-2672.2009.04285
Kusari P, Kusari S, Eckelmann D, Zuhlke S, Kayser O, Spiteller M (2016) Cross-species biosynthesis of maytansine in Maytenus serrata. RSC Adv 6:10011–10016. https://doi.org/10.1039/c5ra25042k
Li J, Zhao GZ, Huang HY, Qin S, Zhu WY, Zhao LX, Xu LH, Zhang S, Li WJ, Strobel G (2012) Isolation and characterization of culturable endophytic actinobacteria associated with Artemisia annua L. Antonie Van Leeuwenhoek 101:515–527
Li X, Huang P, Wang Q, Xiao L, Liu M, Bolla K, Zhang B, Zheng L, Gan B, Liu X, Zhang L, Zhang X (2014) Staurosporine from the endophytic Streptomyces sp. strain CNS-42 acts as a potential biocontrol agent and growth elicitor in cucumber. Antonie Van Leeuwenhoek 106:515–525. https://doi.org/10.1007/s10482-014-0220-6
Managamuri U, Vijayalakshmi M, Ganduri VSRK, Rajulapati SB, Bonigala B, Kalyani BS, Poda S (2017) Isolation, identification, optimization, and metabolite profiling of Streptomyces sparsus VSM-30. 3Biotech 7:217. https://doi.org/10.1007/s13205-017-0835-1
Murugadoss K, Nagarathinam SR, Vinothkanna S, Soundarraj H (2016) A study on tourism potential in Munnar region, Kerala. Int J Innov Res Sci Eng Technol 51:21262-21271. doi: 10.15680/IJIRSET.2016.0512060
Padhi S, Tayung K (2013) Antimicrobial activity and molecular characterization of an endophytic fungus Quambalaria sp. isolated from Ipomoea carnea. Ann Microbiol 63:793–800. https://doi.org/10.1007/s13213-012-0534-4
Prestinaci F, Pezzotti P, Pantosti A (2015) Antimicrobial resistance: a global multifaceted phenomenon. Pathog Glob Health 109:309–318. https://doi.org/10.1179/2047773215Y.0000000030
Rajan BM, Kannabiran K (2014) Extraction and identification of antibacterial secondary metabolites from marine Streptomyces sp. VITBRK2. Int J Mol Cell Med 3:130–137
Ramasubramaniaraja R (2010) Millingtonia hortensis Linn – an overview. Int J Pharm Sci Rev Res 4:123–125
Rao HCY, Rakshith D, Gurudatt DM, Satish S (2016) Implication of PKS type I gene and chromatographic strategy for the biodiscovery of antimicrobial polyketide metabolites from endosymbiotic Nocardiopsis prasina CLA68. Sci Nat 103:45. https://doi.org/10.1007/s00114-016-1370-3
Rao HCY, Rakshith D, Satish S (2015a) Antimicrobial proprieties of endophytic actinomycetes isolated from Combretum latifolium Blume, a medicinal shrub from Western Ghats of India. Front Biol 10:528–536. https://doi.org/10.1007/s11515-015-1377-8
Rao HCY, Santosh P, Rakshith D, Satish S (2015b) Molecular characterization of an endophytic Phomopsis liquidambaris CBR-15 from Cryptolepis buchanani Roem. and impact of culture media on biosynthesis of antimicrobial metabolites. 3 Biotech 5:165–173. https://doi.org/10.1080/21501203.2015.1113207
Rao HCY, Satish S (2016) Intra-specific differentiation of fungal endosymbiont Alternaria longissima CLB44 using RNA secondary structure analysis and their anti-infective potential. Sci Nat 103:69. https://doi.org/10.1007/s00114-016-1389-5
Robertsen HL, Weber T, Kim HU, Lee SY (2017) Towards systems metabolic engineering of Streptomycetes for secondary metabolites production. Biotechnol J 13:27. https://doi.org/10.1002/biot.201700465
Romano S, Jackson SA, Patry S, Dobson ADW (2018) Extending the “one strain many compounds” (OSMAC) principle to marine microorganisms. Mar Drugs 16:244. https://doi.org/10.3390/md16070244
Roy S (2018) Biotechnological significance of endophytic actinobacteria an intensive and emerging pursuance. Adv Biotech Micro 9:001–004. https://doi.org/10.19080/AIBM.2018.09.555767
Saurav K, Kannabiran K (2012) Cytotoxicity and antioxidant activity of 5-(2 4-dimethylbenzyl)pyrrolidin-2-one extracted from marine Streptomyces VITSVK5 spp. Saudi J Biol Sci 19:81–86. https://doi.org/10.1016/j.sjbs.2011.07.003
Schiewe HJ, Zeeck A (1999) Cineromycins, c-Butyrolactones and ansamycins by analysis of the secondary metabolite pattern created by a single strain Streptomyces. J Antibiot 52:635–642. https://doi.org/10.7164/antibiotics.52.635
Ser H, Mutalib AB, Yin N, Chan K, Goh B, Lee L (2015) Evaluation of antioxidative and cytotoxic activities of Streptomyces pluripotens MUSC 137 isolated from mangrove soil in Malaysia. Front Microbiol 6:1398. https://doi.org/10.3389/fmicb.2015.01398
Shan W, Zhou Y, Liu H, Yu X (2018) Endophytic actinomycetes from tea plants (Camellia sinensis): isolation, abundance, antimicrobial, and plant-growth-promoting activities. BioMed Res Int. Article ID 1470305
Sharma M, Puri S, Sharma PD (2007) Antifungal activity of Millingtonia hortensis. Indian J Pharm Sci 69:599–601. https://doi.org/10.4103/0250-474X.36959
Shirling EB, Gottlieb D (1966) Methods for characterization of Streptomyces species. Int J Syst Bacteriol 16:313–340. https://doi.org/10.1099/00207713-16-3-313
Singh JM, Padmavath S (2015) Nocardiopsis sp. 5 endophytic to Tulsi leaves - isolation and antimicrobial activity. Br Microbiol Res J 5:194–202. https://doi.org/10.9734/BMRJ/2015/13523
Siqueria VMD, Conti R, Araujo JMD, Motta CMS (2011) Endophytic fungi from the medicinal plant Lippia sidoides Cham. and their antimicrobial activity. Symbiosis 53(2):89–95. https://doi.org/10.1007/s13199-011-0113-7
Stierle A, Strobel G, Stierle D (1993) Taxol and taxane production by Taxomyces andreanae, an endophytic fungus of pacific yew. Science 260:214–216. https://doi.org/10.1007/s00253-011-3472-3
Subramani R, Aalbersberg W (2012) Marine actinomycetes: an ongoing source of novel bioactive metabolites. Microbiol Res 167: 571580. https://doi.org/10.1016/j.micres.2012.06.005, 571580
Taechowisan T, Lumyong S (2003) Activity of endophytic actinomycetes from roots of Zingiber officinale and Alpinia galena against phytopathogenic fungi. Ann Microbiol 53:291–298
Tansuwanwong S, Yamamoto H, Imai K, Vinitketkumnuen U (2009) Antiproliferation and apoptosis on RKO colon cancer by Millingtonia hortensis. Plant Food Hum Nutr 64:11–17. https://doi.org/10.1007/s11130-008-0094-8
Tong WY, Darah I, Latiffah Z (2011) Antimicrobial activities of endophytic fungal isolates from medicinal herb Orthosiphon stamineus Benth. J Med Plants Res 5:831–836
Upadhyaya A, Nagasatya A, Thajuddin N, Paneerselvam A (2013) Isolation and screening of Streptomyces from the Western Ghats for the presence of amphotericin B. Int J Curr Microbiol App Sci 2:460–465
Ventura M, Canchaya C, Tauch A, Chandra G, Fitzgerald GF, Chater KF, van Sinderen D (2007) Genomics of Actinobacteria: tracing the evolutionary history of an ancient phylum. Microbiol Mol Bio Rev 71:495–548. https://doi.org/10.1128/MMBR.00005-07
Verma VC, Gond SK, Kumar A, Mishra A, Kharwar RN, Gange AC (2009) Endophytic actinomycetes from Azadirachta indica A. Juss.: isolation, diversity and anti-microbial activity. Microb Ecol 57:749–756. https://doi.org/10.1007/s00248-008-9450-3
Vobis G, Kothe HW (1985) Sporogenesis in sporangiate actinomycetes. In: Pathak NC, Singh VP (eds) Front app microbial Springer, New York
Wang C, Wang Z, Qiao X, Li Z, Li F, Chen M, Wang Y, Huang Y, Cui H (2013) Antifungal activity of volatile organic compounds from Streptomyces alboflavus TD-1. FEMS Microbiol Lett 34:45–51. https://doi.org/10.1111/1574-6968.12088
Wang L, Qiu P, Long XF, Zhang S, Zeng ZG (2016) Comparative analysis of chemical constituents, antimicrobial and antioxidant activities of ethyl acetate extracts of Polygonum cuspidatum and its endophytic actinomycete, Streptomyces sp. A0916. Chin J Nat Med 14:117–123. https://doi.org/10.5073/jabfq.2017.090.023
Wang LW, Xu G, Wang JY, Su ZZ, Lin FC, Zhang CL, Kubicek CP (2012a) Bioactive metabolites from Phoma species, an endophytic fungus from the Chinese medicinal plant Arisaemae rubescens. Appl Microbiol Biotechnol 93:1231–1239. https://doi.org/10.1007/s00253-011-3472-3
Wang LW, Xu G, Wang JY, Su ZZ, Lin FC, Zhang CL, Kubicek CP (2012b) Bioactive metabolites from Phoma species, an endophytic fungus from the Chinese medicinal plant Arisaema erubescens. Appl Microbiol Biotechnol 93:1231–1239. https://doi.org/10.1007/s00253-011-3472-3
Zhao K, Penttinen P, Guan T, Xiao J, Chen Q, Xu J, Lindström K, Zhang L, Zhang X, Strobel GA (2011) The diversity and anti-microbial activity of endophytic actinomycetes isolated from medicinal plants in Panxi plateau, China. Current Microbiol 62:182–190. https://doi.org/10.1007/s00284-010-9685-3
Acknowledgments
The authors thank the Indian Council of Medical Research (ICMR), New Delhi, for the award of Senior Research Fellowship (No.3/2/2/65/2018/Online Onco Fship/NCD-III) to the first author. We are grateful to the Centre for Nano Science and Engineering (CeNSE), the Indian Institute of Science (IISc), Bengaluru, for the scanning electron microscopic analysis. The first author thanks Dr. R. Sundararaj, Scientist – G, Forest Protection Division, Institute of Wood Science and Technology for his support. We also thank the Department of Studies in Microbiology, University of Mysore, for providing laboratory and instrumentation facilities.
Author information
Authors and Affiliations
Corresponding authors
Ethics declarations
Conflict of interest
The authors declare that they have no conflict of interest
Additional information
Communicated by: Matthias Waltert
Publisher’s note
Springer Nature remains neutral with regard to jurisdictional claims in published maps and institutional affiliations.
Electronic supplementary material
ESM 1
(DOCX 224 kb)
Rights and permissions
About this article
Cite this article
Mondal, S., Rai, V.R. Molecular profiling of endophytic Streptomyces cavourensis MH16 inhabiting Millingtonia hortensis Linn. and influence of different culture media on biosynthesis of antimicrobial metabolites. Sci Nat 106, 51 (2019). https://doi.org/10.1007/s00114-019-1646-5
Received:
Revised:
Accepted:
Published:
DOI: https://doi.org/10.1007/s00114-019-1646-5




